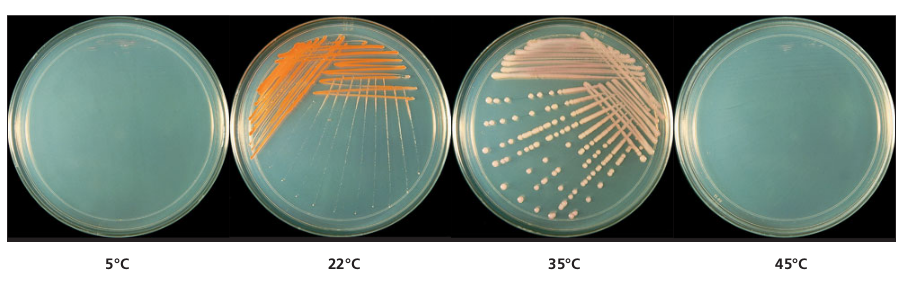
- A nutrient agar plate inoculated with a mesophile and incubated at different temperatures. Effect of temperature on the growth and pigmentation of the isolate can be seen clearly. (Image source: Ref-2)

Microbes are loosely classified into several groups based on their preferred temperature ranges. Every organism has a range of permissive growth temperatures. Unlike pH or osmolarity, microbes cannot regulate their temperature i.e. their internal temperature matches that of the surrounding environment. Any changes in temperature have the biggest effect on enzymes and their activity.
- Minimum growth temperature: The lowest temperature at which the organism can survive and replicate. If the environmental temperature is lower than the optimal temperature, it leads to a decrease in enzyme activity and a slower metabolism.
- Optimum growth temperature:Â The growth rates are the highest at optimum growth temperature as it leads to the fastest metabolism. Â
- Maximum growth temperature:Â Â The highest temperature at which growth can occur. Â Higher temperatures can denature proteins such as enzymes and carrier proteins, leading to cell death.

The following ranges of permissive growth temperatures are approximate only and can vary according to other environmental factors.
Psychrophiles
Psychrophiles are “Cold-loving” organisms, they can grow at 0°C. Based on their permissive temperature, psychrophiles can be broadly classified into two groups: True psychrophiles and psychrotrophs.
- True psychrophiles: They are sensitive to temperatures over 20°C. Optimum growth occurs at 15°C or below. Found in very cold environments such as ocean depths, Arctic, and the Antarctic regions. They seldom cause disease or food spoilage. Â
- Psychrotrophs (also known as psychrotolerant): Psychrotroph is a variant of psychrophile, which grows at 0°C but displays an optimum temperature in the mesophile range, nearer room temperature (15-25°C). They are found in many natural environments in temperate climates and are responsible for the spoilage of refrigerated food.
Psychrotrophs are the scourge of food storage in refrigerators since they are brought in from their mesophilic habitats and continue to grow in the refrigerated environment ( 4°C ) where they spoil the food e.g., Listeria monocytogenesgrows in the guts of cattle, can contaminate beef, milk and crops but unlike typical mesophilic human pathogens, it grows at refrigerated temperatures.
Psychrophilic proteins rapidly denature above their temperature optima and cannot function at body temperatures of warm-blooded animals (37°C) so psychrophiles are unable to grow at even moderate temperatures.
Psychrophiles and psychrotrophs are important decomposers in cold climates and their enzymes are of interest to biotechnology.
Survival Strategy of Psychrophiles
- Psychrophiles contain specific proteins, particularly enzymes that can still function (albeit at a reduced rate) in low temperatures (at temperatures at or near 0 °C ). These enzymes are more flexible than their mesophilic and thermophilic homologues and they have more accessible catalytic sites to accommodate slower diffusion rates.
- To maintain the semifluid consistency of the plasma membrane at low temperature, psychrophiles have an increased amount of unsaturated and shorter-chain fatty acids in their plasma membranes.  Some psychrophiles, particularly those from the Antarctic have been found to contain polyunsaturated fatty acids.
- Psychrophiles  also produce cryoprotectants: special proteins or sugars that prevent the development of damaging ice crystals
Fatty acid saturation vs membrane fluidity of microorganismsNature and state (liquid or solid) of fatty acids present in the membrane affects its function. The degree of unsaturation of a fatty acid correlates with its solidification temperature or thermal transition stage (i.e., the temperature at which the lipid melts or solidifies);unsaturated fatty acids remain liquid at low temperatureas “kinks” in their tails push adjacent phospholipid molecules away. So, organisms who need to survive at cold temperature should contain higher proportion of unsaturated fatty acids in their membrane.In lower temperature,saturated fatty acidspress in on each other, making a dense and fairly rigid membrane but theyare stable at high temperatures.So organisms having higher proportions of saturated fatty acids in their cell membrane can not grow at lower temperature but can thrive at higher temperature.Thus, saturated fatty acids (like butter) are solid at room temperature while unsaturated fatty acids (like safflower oil) remain liquid in the refrigerator.
Mesophiles
Mesophiles “middle loving” are microorganisms with an optimum temperature near 37°C (the body temperature of warm-blooded animals). Mesophiles can grow in the temperature range of 25-40°C. Most of the pathogenic microorganisms and normal human microbiota are mesophiles. E.g. human bacterial pathogens such as *Staphylococcus aureus, Escherichia coli, Streptococcus pneumoniae, Streptococcus pyogens,*and Haemophilus influenzae.
Thermophiles
Thermophiles are “heat-loving” organisms having optimum growth between 50-60°C. Many thermophiles cannot grow below 45°C. Some thermophiles form extremely heat-resistant endospores. Examples of thermophiles include Thermus aquaticus and Geobacillus spp. Thermophiles are widely distributed in hot springs, geothermal soils, sunlit soil and manmade environments such as garden compost piles where the microbes break down organic waste.

Extreme thermophiles (also known as hyperthermophiles) have optimum growth at 80°C or higher. The permissive growth temperature for hyperthermophiles ranges from 80°C to a maximum of 110°C, with some extreme examples that survive temperatures above 121°C, the average temperature of an autoclave. They are mostly Archaebacteria and are found in volcanic and ocean vents. Â
Survival Strategy of Thermophiles
- Thermophiles require specialized heat-stable enzymes that are resistant to denaturation and unfolding. In contrast to their psychrophilic homologues, enzymes/proteins of thermophiles are more tightly folded, making them less flexible with a less accessible catalytic site. The enzymes of these organisms are also of interest to biotechnology. It was the discovery of Thermus aquaticus that led biochemist Kary Mullis to invent the revolutionary molecular technique PolymeraseChainReaction (PCR), using the organism’s heat-active DNA polymerase (the Taqpolymerase).
- The structural proteins (e.g. ribosomal proteins, transport proteins (permeases) and enzymes of thermophiles and hyperthermophiles are very heat stablecompared with their mesophilic counterparts. The proteins are modified in a number of ways including dehydration and through slight changes in their primary structure, which accounts for their thermal stability.
- To maintain the stability and functionality of the plasma membrane at a higher temperature, the membrane lipids of thermophiles contain a **high content of saturated fatty acids.**Due to their linear structures, saturated lipids pack more tightly, giving a more organized membrane and increasing its melting temperature.
- Thermophiles express protective chaperone proteins to help with protein folding and to help maintain their native structure. In addition, the ether linkage of the thermophilic and hyperthermophilic archaea is more thermostable than the ester linkage of phospholipids.
- The membranes of hyperthermophiles, virtually all of which are Archaea, are not composed of fatty acids but of repeating subunits of the C5 compound, phytane, a branched, saturated, “isoprenoid” substance, which contributes heavily to the ability of these bacteria to live in superheated environments.Â
- The high thermal stability of the hyperthermophilic archaeal membranes is also due to their tetraether monolayer structure, as the inner and outer layers of a membrane bilayer will separate under very high temperatures.
References and further readings
- Madigan Michael T, Bender, Kelly S, Buckley, Daniel H, Sattley, W. Matthew, & Stahl, David A. (2018). Brock Biology of Microorganisms (15th Edition). Pearson.
- Cappuccino James G and Sherman N. Microbiology: A Laboratory Manual. 10th edition. Pearson Education.